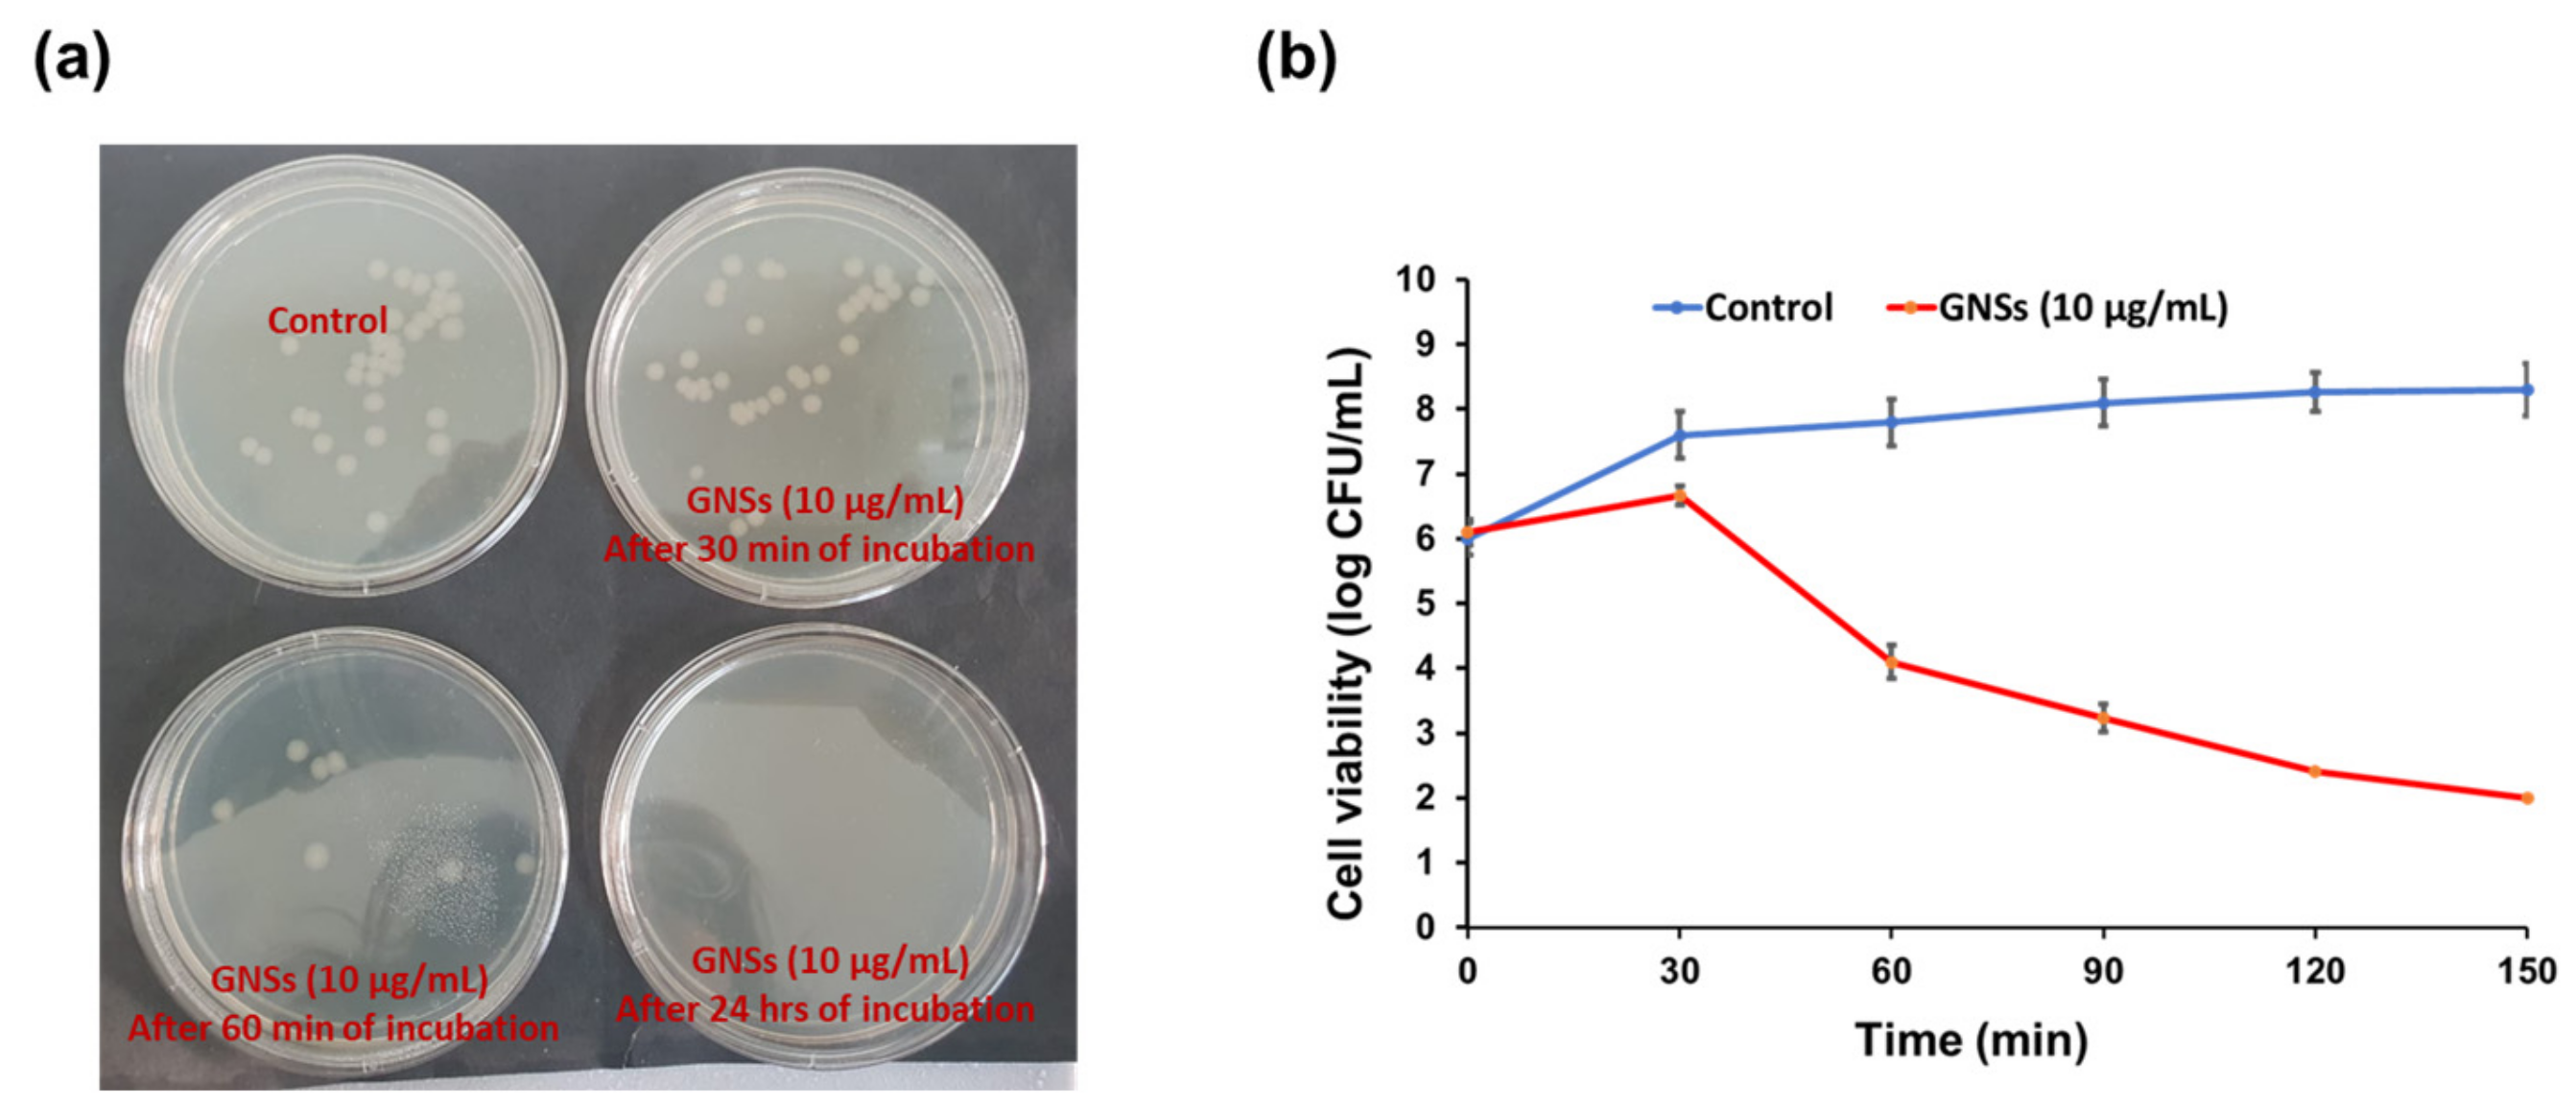
Catalysts 13 01077 g005

Abstract
In recent years, the application of biocompatible and non-toxic nanomaterials for the detection of fingerprints has become the major interest in the forensic sector and crime investigation. In this study, waste chickpea seeds, as a natural resource, were bioprocessed and utilized for the synthesis of non-toxic graphene nano-sheets (GNSs) with high fluorescence. The graphene GNS were synthesized via pyrolysis at high temperatures and were characterized by TEM, XPS, fluorescence and UV-Vis spectroscopy, and FTIR analysis. The GNS exhibited excitation-independent emission at about 620 nm with a quantum yield of over 10% and showed more distinct blue light under a UV lamp. Biocompatibility of the synthesized GNS in terms of cell viability (88.28% and 74.19%) was observed even at high concentrations (50 and 100 mg/mL), respectively. In addition, the antimicrobial properties of the synthesized GNS-based coatings were tested with the pathogenic strain of Bacillus cereus via live/dead cell counts and a plate counting method confirming their biocompatible and antimicrobial nature for their potential use in safe fingerprint detection. The developed chickpea-originated fluorescent GNS-based spray coatings were tested on different surfaces, including plastic, glass, silicon, steel, and soft plastic for the detection of crime scene fingerprints. Results confirmed that GNS can be used for the detection of latent fingerprints on multiple non-porous surfaces and were easy to detect under a UV lamp at 395 nm. These findings reinforce the suggestion that the developed fluorescent GNS spray coating has a high potential to increase sensitive and stable crime traces for forensic latent fingerprint detection on nonporous surface material. Capitalizing on their color-tunable behavior, the developed chickpea-originated fluorescent GNS-based spray coating is ideal for the visual enhancement of latent fingerprints.
1. Introduction
Fingerprint analysis, also known as dactyloscopy, is by far the most popular identification technique and has been utilized extensively in police prosecutions for more than a decade. The fingerprint is the main evidence in forensic science because each person has a distinct pattern of epidermal ridges on their fingers; hence, no two entities have the same type of fingerprints. When a person touches any kind of solid surface, it leads to the transfer of natural skin secretions and exogenous residues present on the fingers to those surfaces. This transfer forms finger impressions on the surface [1]. Ridge patterns that have been electronically or manually recorded are kept in national archives so that impressions discovered at crime scenes can be automatically compared to the police database [2]. The exploitation of fingerprints to identify the crime, criminals, and victims is an old detection strategy and has been used as a seal on documents for the identification of the artist who made the painting or pottery. It is an advanced part of the organization for biometric applications, which are quickly gaining acceptance in commonplace applications ranging from access control to digital authentication of electronic devices for homeland security [3,4,5].
The identification of finger impressions has played a major role in criminal investigations, due to its uniqueness. Latent prints present at the crime scene need attention and detection methods [6]. Early detection techniques based on ninhydrin, silver nitrate, iodine vapor, cyanoacrylate deposition, and vacuum metal deposition have been used successfully and are still being used in forensic labs to create latent fingerprints. When it comes to fingerprint dusting at crime scenes, materials based on aluminium, silica, titanium dioxide, and magnetic particles have been employed for decades [7]. These methodologies have several limitations in that not all levels of fingerprints have been established, they are poisonous, have strong autofluorescence incursion, interact with the background, and have indistinct ridges. Such limitations in conventional materials demand a novel, sustainable, and less toxic method to develop the fingerprints, which increase the accuracy of hidden finger impressions, lower their cost, and increase their effectiveness in assisting with investigations by identifying the offender [8,9].
Nanoscience has offered a sustainable solution and provided nanomaterials as a potential tool for the development of dormant finger impressions which helps in the personal identification and characterization of suspects and criminals who are connected to one another or the crime scene [7]. A few advantages of nanoparticles are high sensitivity, low toxicity, and high contrast pictures, some of which are also economically advantageous. Nanoparticles can physically bond by chemically interacting with the amino acids, fatty acids, and other water-soluble substances present in the impressions [10]. Additionally, nanomaterials also possess photoluminescence properties. To enhance the hidden finger marks, scientists utilize nanoparticles made of gold, silver, titanium dioxide, zinc oxide, silica, etc. These nanoparticles have given better results than the conventional methods as they develop class, individual characteristics and the pores present in fingerprints [11].
In recent years, graphene sheets and other carbon-based nanomaterials have gained importance due to the specificity of zero-dimensional carbon materials consisting of sp2/sp3 hybridized carbon atoms in the core with abundant functional groups on the shell and exhibited composition-dependent fluorescence properties. Graphene-based materials trigger great concern in a wide range of applications ranging from bio-imaging, sensing, drug delivery, photocatalysis, energy storage, and fluorescent ink to disease diagnosis due to their unique properties, such as robust chemical inertness, non-toxicity, extreme biocompatibility, and great stability without photobleaching. However, low fluorescent quantum yields demand subsequent strategies, including functionalization or surface passivation to enhance the optical properties of GNSs. Currently, heteroatom-doped graphene nanomaterials are a hotspot; this provides a feasible and facile way to tune their intrinsic properties to achieve new and multifunctional applications. In this line of interest, a few researchers have explored the applications of graphene-based nanomaterials for fingerprinting applications.
GNSs have a strong adherence to fingerprint residues as well as high-resolution imaging and improved visibility. Due to their robust photoluminescence, simple synthesis, simple surface functionalization, great chemical stability, and good water solubility, graphene nano-sheets (GNSa) have garnered a lot of interest. Due to the lack of metals, GNSs also exhibit comparatively low toxicity and superior biocompatibility when compared to conventional organic dyes and semiconductor quantum dots. GNSs and other graphene-based nanomaterials have been used extensively in energy conversion, optical sensing, and imaging systems [12]. The key to the ability of graphene-based compositions to recover fingerprints is their capacity to change color when exposed to various light sources, allowing background-free photos and maximizing the accuracy of fingerprint analysis. The use of a diluent matrix, the creation of core-shell nanostructures, the incorporation of heteroatom doping, the utilization of effects, such as resonance energy transfer and interactions, the use of molecular spacers, and other techniques have been suggested to combat the tendency of graphene or other carbon-based nanomaterials in the solid state for self-quenching [13,14]. Fernandes et al. were the first to demonstrate the use of carbon nanomaterial-based powders for fluorescent visualization of dormant finger impressions. They showed that the incorporation of 0.7 wt.% carbon nanomaterials into a silica matrix allowed a highly detailed and color-tunable visual display of dormant finger impressions on a glass slide as well as on a multicolor soft drink label [15,16].
The nanometer-sized GNSs, which have minimal toxicity, biocompatibility, and water solubility, are a subset of the nanomaterial class. Several applications, including bioimaging, drug delivery, gene transfer, metal ion detection, sensing, and nano-thermometry, can make use of the photoluminescence properties of graphene and other carbon nanomaterials [17]. The colloidal stability of GNS dispersions in a variety of liquid media suggests that GNS-based sprays give effective results [18,19]. Although attempts have been made to increase the detection limit of latent fingerprints (LFPs) by using fluorescent nanomaterials, such as carbon nano rods, quantum dots, carbon dots, and up-conversion nanoparticles, issues still persist due to their poor detection performance, difficult manufacturing process, photobleaching, and toxicity. There is a need to develop more efficient and cost-effective graphene nanomaterials using easy methods. Therefore, in this study, to overcome the aforementioned limitations, a feasible approach to develop biomass-originated GNSs with no toxicity and antimicrobial efficiency for their further potential application in the detection of latent finger impressions was attempted.
2. Results
2.1. Synthesis and Characterization of the Synthesized GNS
The pyrolysis of chickpea was performed at 800 °C for 2 h which yielded a black powder. Further, the water solubility of as-synthesized GNS was achieved using mild acid treatment with concentrated nitric acid (Figure 1). Oxidation endows GNSs with high-density negative surface functionalities along with PL properties.
Figure 1.
Brief representation for the synthesis of chickpea-originated fluorescent GNSs.
2.2. Characterization of GNS
2.2.1. Morphological Characterization
The morphology of GNSs was characterized using transmission electron microscopy (HR-TEM (FEI Tecnai F30, Hillsboro, OR, USA) analysis. The typical TEM image shown in Figure 2a shows the spherical nature of a GNS without any other morphological impurities. GNSs are in the size range of 10 to 50 nm as calculated statically (Figure 2b). The HR-TEM image in Figure 2c shows the graphitic nature of GNSs. The missing graphitic planes are marked by white circles. The distance between two adjacent lattice fringes is 0.31 nm ascribed to a good degree of graphitization by Das et al. [19].
Figure 2.
(a) Low-resolution TEM image of GNS; (b) high-resolution TEM image of GNS; (c) HR-TEM image of GNS showing interlayer spacing; (d) FTIR spectrum of GNS; (e) Raman spectrum of GNS; (f) XRD spectrum of GNS.
2.2.2. Structural Characterization
The sheet-like morphology of GNSs was recognized using TEM analysis, as shown in Figure 2a. GNSs were composed of a few layers of graphene with various folds and crumps. The high magnification TEM image in Figure 2b shows the high density of surface defects, which are marked with white arrows. The HRTEM image in Figure 2c shows the presence of missing graphic planes as marked with a white circle. GNSs have lattice fringes of 0.31 nm as shown in Figure 2c. Surficial functional groups of GNSs were identified with Fourier transform-infrared (FTIR) spectroscopy (Figure 2d). The development of a π conjugated structure was confirmed using the existence of the aromatic C=C vibrations peak centered at 1609 cm−1 and in-plane bending vibrations of aromatic C–H at 563 cm−1 [20]. The broad band at 3435 cm−1 was assigned to the stretching vibrations of the O–H. The peaks at 2917 cm−1 and 2851 cm−1 are ascribed to the aliphatic C–H stretching, and the merged peak centered at 1726 cm−1 is attributed to C=O stretching [21,22]. The band at 573 cm−1 corresponds to bending vibrations of =C–H. Peaks at 1120 cm−1 and 1039 cm−1 are ascribed to C–O and C–C stretching vibrations, respectively. The FTIR spectrum revealed the co-existence of high density of oxygenous functional groups, which enables better stabilization of GNSs in water. The characteristic D band (high intensity) and G band (low intensity) are observed in Raman spectra of GNSs (Figure 2e), which clearly reflect the defective nature of GNSs [23]. The XRD pattern of GNSs is shown in Figure 2f, which exhibits a broad peak at 2θ = 24.8° and another weak peak at 2θ = 44°, which represents the (002) and (100) plane of carbon [24].
2.2.3. Optical Characterization
The UV-Vis absorption spectrum of GNSs, as shown in Figure 3a, shows an evident absorption band at ~357 nm with a continuous tail through the entire visible region with a hump at 514 nm, ascribed to π-π* and n-n* transitions of conjugated C=C and C=O. The absence of any background absorption indicates that there is no other morphological impurity [25]. The light-yellow colored solution of GNSs showed blue emission under the irradiation of UV light (Figure 3b). The PL spectra in Figure 3c indicate typical excitation-independent emission spectra ranging from 360 to 620 nm excitation wavelengths at a continuous increment of 20 nm. The maximum emission was centered at ~650 nm, while the maximum emission intensity was observed at ~475 nm. Excitation wavelength-dependent emissions of GNSs are attributed to the different photon absorption mechanisms. PL excitation spectrum of GNSs at 475 nm excitation wavelength (Figure 3d) showed four different peaks at 295, 360, 373, and 423 nm, which indicates the presence of multiple emissive centers in GNS [26].
Figure 3.
(a) UV-Vis absorption spectrum of GNS; (b) synthesized fluorescence nanostructures of GNSs under daylight (left) and UV lamp (right); (c) emission spectra of GNS excited by different wavelengths. (d) PL excitation spectrum of GNS at 475 nm excitation wavelength. Photostability test of GNSs; (e) at continuous irradiation of s UV light (365 nm) irradiation and (f) in the presence of high ionic strength of Na+, K+, Ca2+, and Mg2+.
The quantum yield of GNSs was measured to be 22% with reference to quinine sulfate, indicating the strong quantum confinement of particles. The optical properties of GNSs were also investigated under the continuous irradiation of high intensity UV light and in the presence of high ionic strengths. The emission intensity centered at 475 nm remained almost similar after 1 h continuous irradiation of UV light, as shown in Figure 3e. No perceptible changes in the PL emission intensity were observed under the influence of high ionic strength (0.5 M to 3.5 M) with Na+, K+, Ca2+, and Mg2+ as shown in Figure 3f. GNSs exhibited good photostability without any change in visual appearance after several months when stored in a closed vessel at room temperature. Hence, GNSs could be a potential PL probe at various physical salt concentrations.
2.3. Biocompatibility/Toxicity Measurements
The biocompatibility and cytotoxicity of the chickpea-originated fluorescent GNSs were examined by observing their non-killing effect on cell lines as confirmed by the cell viability measurements via an MTT enzyme assay and cellular morphological characteristics of normal bronchial epithelial cells (BEAS-2B). Different concentrations of fluorescent GNSs ranging from 10 to 50 μg/mL showed no toxicity toward BAES-2B epithelial cells when tested with an MTT enzyme assay (Figure 4a,b). Briefly, the percentages of live/viable cells at higher concentrations of GNSs (25 and 50 μg/mL) were observed above 95% (Figure 4). In addition, negligible changes in the morphology of the treated BAES-2B cell lines were observed after exposure at high concentrations (25 and 50 μg/mL) compared to untreated cells (control). Interestingly, it was observed that at the highest concentration (50 μg/mL), there was a deposition of the GNS matrix; however, it did not show any toxicity to the cells.
Figure 4.
Biocompatibility/cytotoxicity of synthesized graphene nano-sheets (GNS) (a) % cell viability based on cell counts; (b) morphology of BEAS-2B cells after treatment and control test.
2.4. Antimicrobial Spectrum of GNS
2.4.1. Inhibitory Effects of GNSs on B. cereus Cell Growth Kinetics
In this assay, GNSs demonstrated strong inhibitory activity against B. cereus in the form of no colony growth with a minimal concentration of 10 μg/mL after 24 h of interaction with B. cereus (106 CFU/mL) (Figure 5a). The bacterial killing kinetics of GNSs suggest a significant (p < 0.001) and time-dependent decrease in the viable count of B. cereus as compared to the control. As depicted in Figure 5, a sharp 2-fold (4.11 log CFU/mL) time-dependent reduction in viable cell count was observed after 60 min of GNS treatment, and 3-fold inhibition was observed after 150 min of incubation (Figure 5b). Similarly, after 24 h, complete inhibition of viable colonies was observed (Figure 5a). On the other hand, the viable count remained almost static throughout the experimental period in untreated control cells.
Figure 5.
Anti-bacterial efficiency of as-synthesized GNS. (a) viable cell counts after incubation of B. cereus (106 CFU/mL) with GNS (10 μg/mL); (b) bacterial killing kinetics as per time-dependent activity.
2.4.2. Fluorescence Staining
Acridine orange/ethidium bromide (AO/EB) fluorescence staining was performed after treatment of pathogenic B. cereus (106 CFU/mL) at the MIC (10 μg/mL) of GNSs. The inhibitory effect of GNSs was confirmed by the presence of highly red-colored fluorescence, thereby confirming their toxicity to cells of pathogenic B. cereus (Figure 6). Generally, in AO/EB staining, AO stains live cells, while EB stains cells that have lost their membrane integrity. AO-stained cells give a green fluorescence representing live cells, while EB gives a red fluorescence denoting dead cells. All experiments were repeated three times independently and at least three different fields were observed for each culture.
Figure 6.
Live/dead cell population of B. cereus after treatment with GNS.
2.5. Development of Quiescent Finger Impressions Using GNS
Spraying or coating is a basic physical technique to bond the liquid to perspiration and greasy materials, such as oil and grease in the fingerprint impression. Due to the presence of perspiration and oil in the fingerprint residue, GNSs were physically adsorbed into the ridges made on the surface during imprinting at a better level. The fingerprint pattern was then revealed again when the fluorescent GNSs in the fingerprints were subjected to 365 nm UV light.
2.6. Development of Latent Fingerprints by Using GNS
The dormant finger impressions were developed on five different porous and non-porous surfaces, including glass slide, paper, marble, steel plate, and plastic plate using GNSs (Table 1). GNSs showed good results on plastic, steel, and paper surfaces as the finger-mark residue remains suspended on the surface (Figure 7). It gave a clear image of a fingerprint with a distinct clarity of ridge characteristics, whereas the prints developed on the marble and glass surfaces showed the fingerprint pattern, but the ridge characteristics were not clear (Figure 7 and Figure 8). A black-and-white filter was applied to obtain a clear image and detailed ridges (Figure 8).The developed finger impressions showed level I (pattern) and level II details (individual characteristics—bifurcation, trifurcation, dot etc.) (Figure 9 and Figure 10). Whereas level III (sweat pores) details were also visible in it (Figure 11).
Table 1.
Latent finger impressions developed using GNS.
Figure 7.
Developed fingerprints on various non-porous and porous surfaces using GNS.
Figure 8.
Developed fingerprints on various non-porous and porous surfaces using GNS (with black and white filter).
Figure 9.
Visible individual characteristics on plastic surface showing bridge, ridge return, and divergence.
Figure 10.
Visible individual characteristics on paper (porous surface) showing dot, bridge, and ridge ending.
Figure 11.
Visible individual characteristics on marble (non-porous surface) showing ridge recurve, fragmented ridges, enclosure, and bridge with level III characteristics.
3. Materials and Methods
3.1. Chemicals and Reagents
All laboratory-grade reagents were acquired from commercial suppliers and used without any further processing or purification. Hydrochloric acid (HCl), methanol, ethyl acetate, mercuric chloride, and ethanol were of analytical grade (AR), and purchased from Merck (Mumbai, India). Millipore water (18.2 MΩ cm at 25 °C) was used for the preparation of all aqueous solutions. Whatman® Grade 1 filter papers were purchased from Sigma-Aldrich (St. Louis, MO, USA).
3.2. Sample Collection
The specimens for this study were given by selected people (2 female and 2 male). Each participant was instructed to wash their hands with soap and water. After which, the fingers were placed on various surfaces (both porous and non-porous surfaces). Each participant’s full and incomplete fingerprints were obtained on these surfaces.
3.3. Synthesis of Graphene Nano-Sheets (GNS)
Water soluble graphene nano-sheets (GNS) were synthesized using chickpeas as a precursor using the pyrolysis technique described earlier with some modifications [4]. Briefly, 2 g of a powdered chickpea sample was put in a capped quartz boat and heated at 800 °C for 2 h at a heating rate of 5° min−1 under an inert environment created with the flow of nitrogen. Such synthesized soot was collected and treated with nitric acid to introduce hydrophilic groups. Typically, 1 g of soot was taken in 100 mL nitric acid (60%) and refluxed for 12 h. The supernatant was collected via centrifugation and evaporated in a water bath until a slurry was formed. Afterward, 500 mL of water was added to it and evaporated. This process was repeated to remove excess acid. When the pH reached 7.0, the slurry was dried at room temperature and the GNSs were collected (Yield 60%).
3.4. Characterization of Synthesized GNSs
The microstructure and morphology of as-synthesized GNSs were characterized using TEM and HR-TEM (FEI Tecnai F30, Hillsboro, OR, USA) operated at 300 kV). Optical absorption of GNSs was collected in an aqueous solution using a Varian 50 Bio UV-Vis spectrophotometer (Palo Alto, CA, USA). Emission spectra of GNSs were collected with a Varian fluorescence spectrometer in an aqueous solution at room temperature. Photoluminescence (PL) images of the aqueous solution of GNSs were acquired with a Leica inverted optical microscope (Leica DM 2500, Leica Microsystems Ltd., Wetzlar, Germany) on a glass plate. FTIR was performed with a Bruker Vector 22 spectrometer, Billerica, MA, USA.
3.5. Cell Lines Experiments for Cytotoxicity and Morphological Evaluation of GNSs
Bronchial epithelium cells (BEAS-2B) were cultured in RPMI-1640 medium, supplemented with 10% (v/v) fetal calf serum and 1% penicillin–streptomycin cocktail at 37 °C in a 5% CO2 incubator. The cytotoxic effect of GNS was first determined with an MTT assay. Briefly, 6 × 104 BEAS-2B cells per well were incubated in the presence of various concentrations of GNSs (5–50 μL/mL) at 37 °C in a CO2 incubator for 24 h. After incubation, cells were treated with pre-developed MTT solution (5 mg/mL) to produce dark blue-colored formazan crystals and dissolved in 50 μL of dimethyl sulfoxide (DMSO). Finally, absorbance at 540 nm was measured using a multi-microplate reader.
3.6. Bacterial Strain and Antibacterial Efficiency of GNSs
A food-hazardous pathogen Bacillus cereus was used as the target pathogen in the present study. It was grown in Luria–Bertani (LB) medium (Acumedia, Lansing, MI, USA) at 37 °C and maintained on LB agar at 4 °C. To reactivate the strain, the culture was taken out, and a loop full of cells was inoculated into fresh LB medium followed by incubation at 37 °C for 24 h. All sub-cultures were maintained in the LB medium. In all experiments, phosphate-buffered saline (PBS) was used as a negative control. Experimental results were confirmed after triplicate data sets.
3.6.1. Antibacterial and Bacteria-Killing Kinetics of GNSs
To determine the antibacterial activity, the synthesized GNSs were prepared in different concentrations in LB broth ranging between 0 and 50 μg/mL. Finally, an inoculum of the mid-log phase of B. cereus (106 cells/mL) was added to each dilution and incubated at 37 °C. After 24 h, the concentration of GNSs that led to no visible growth was considered to be the effective concentration to kill the bacterial population. In order to confirm the visual growth reduction, the colony counting assay was performed in LB agar media via the pour plating method.
The time-dependent mortality of B. cereus in the presence of GNSs was also assessed. Briefly, tubes containing LB broth with GNSs at the effective concentration were inoculated with bacterial cells (106 cells) and incubated at 37 °C. At different time points (0, 30, 60, 90, and 120 min), 100 μL of the culture was withdrawn, serially diluted, and spread onto LB agar plates. Viability was assayed by counting the cells on the LB plates after incubation at 37 °C for 24 h. Similarly, control tubes containing bacterium without GNSs were set up under the same experimental conditions, and the experiment was performed using three replicates.
3.6.2. Fluorescence Microscopy Staining Assays for Live/Dead Bacterial Cells
The numbers of live and dead cells were evaluated using an acridine orange/ethidium bromide (AO/EB) fluorescent staining. B. cereus cells (106 cells/mL) grown overnight were treated with or without GNSs (at MIC and 2 × MIC) for 60 min at 37 °C (based on pre-optimized conditions). After incubation, the cells were harvested using centrifugation, washed with PBS, and stained with the solution provided with Live/Dead ® BacLightTM Bacterial Viability Kit L13152 (Invitrogen, Carlsbad, CA, USA) Mfor 15 min in the dark. After incubation, the cells were washed with PBS, and images were obtained using confocal laser scanning microscopy, which were then processed with a Zeiss LSM Image Examiner (Oberkochen, Germany, Version 4.2.0.121). All experiments were repeated three times independently and at least three different fields were observed for each culture.
3.7. Application of GNSs for Detection of Fingerprints
For the purpose of assessing felonies, the synthesized GNSs were evaluated for their capacity to detect finger impressions on various surfaces (porous, semi-porous, and non-porous). In brief, a hairbrush was used to apply the GNS nano-powder to different surfaces. The substances secreted by the sebaceous, eccrine, and apocrine glands that result in a finger impression were left on the surface. To develop the prints on the surface, hairbrush strokes were applied. The fluids were discovered in finger impressions on the surface after wiping fingertips across the nose and forehead.
By using a hairbrush, nano-powder of GNS was dispersed to the multiple substrates that retained latent finger impressions. The white color of the nano-powder contrasted well with both colored and dark surfaces. The latent fingermarks developed using nano-powder produced ridge features with little background disturbance. All the experiments in this research were performed in triplicate and the results are compiled as mean ± S.D.
4. Discussion
The GNSs can be used on porous and non-porous surfaces, as they give distinct results on both surfaces. In this study, GNSs developed hidden finger impressions on non-porous surfaces (plastic, marble, glass, and steel) and porous surface (paper) with a clear appearance of class and individual characteristics as well as pores (Figure 2 and Figure 3). The outcome may be due to the reaction between carbon and the phosphate present in the sweat, as also reported by Yang et al. [12]. Similar studies have been conducted by several scientists to show the importance of carbon nanomaterials, including carbon dots (CDs) in the development of latent fingerprint impressions [27,28]. On the majority of non-porous surfaces, such as glass, metal, tiles, and porous surfaces, such as paper, the carbon quantum dots were found to provide clear and precise images of latent finger impressions with little background discoloration, exposing outstanding ridge characteristics. Using the synthesized carbon quantum dot nanoparticle liquid formation showed excellent visibility of minute details or ridges. A few other compositions of graphene nanomaterials and CDs were also investigated for such fingerprinting purposes by Chen et al. [17], where researchers combined 1% CDs with starch powder and discovered comparable encouraging outcomes for the fluorescence imaging of latent fingerprints on a variety of non-porous substrates [17].
Similar to the current research, Nugroho et al. [28] developed graphene/carbon dots from Magnolia grandiflora at various times (14, 16, 18, and 20 min) and further surface-functionalized with hydrogen sulfide (H2S) to synthesize S-doped carbon quantum dots (CQDs). The synthesized S-doped CQDs had a uniform size, according to TEM analysis, along with an amorphous structure and water solubility, and also contained hydroxyl and carboxyl groups, excitation light-dependent characteristics, and high photostability. Synthesized S-doped-carbon nanomaterials have been used in latent fingerprint detection. This study used S-doped carbon/graphene nanomaterials derived from natural resources as high-performance fluorescent probes for the detection of latent fingerprints on non-porous surface materials [17,18].
In several studies, graphene or carbon nanomaterials, a particular class of semiconductor materials that are generated by group II–VI binary compounds at a nanoscale (2–20 nm) size in three dimensions, have been utilized for fingerprint development. CdS, CdSe, and CdTe quantum dots (QDs) have been shaped for creating hidden fingerprints with high sensitivity and outstanding background contrast. The nature of cadmium is highly toxic, which raises the major concern about using cadmium (Cd)-containing quantum dots [29]. Considering the toxic effects of fluorescent cadmium dots, the biomass-generated graphene nano-sheets (GNSs) will facilitate environmentally friendly properties. In similar aspects, Weng et al. [30] designed reduced graphene oxide (rGO) film to form a wrinkled structure using a facile stretching-releasing process, which mimics the morphology of fingertip skin and provided special impacts on crime detection [30]. Further, Zhang et al. [31] also developed latent fingerprints using electrodeposition of GNSs on multiple surfaces and observed that better fingerprints could be achieved by electrodeposition parameters (reaction time, concentration, potential, and scan rate) of graphene, which is significant for the development latent fingerprints samples on various metal surfaces [31]. However, these techniques are complicated to fabricate as compared to the developed graphene nano-sheet-based simple fabrication and fingerprint detection.
5. Conclusions
The fingerprint is a unique identity of an individual since it is an unchangeable feature that differs from person to person. Conventional techniques have somewhere failed to detect old fingerprints and are less stable. Therefore, we have developed biocompatible and biomass-generated graphene nano-sheets (GNSs) that produce blue color under a UV lamp by comparing them with several techniques and these GNSs were successfully applied for the detection of fingerprints on porous and non-porous surface materials. Based on the above findings, it could be concluded that the fingerprint pattern could be improved more clearly under commercial UV lamps with bright blue fluorescence intensity. Therefore, this research has proved that the GNSs derived from plant/grain material have better potential as fluorescent probes for latent fingerprint detection. The application of the powdered GNSs was carried out with experiments on various non-porous materials (glass, plastic, silicon, steel, soft plastic, etc.) with the understanding that the developed fingerprints on various surfaces will also be helpful in food packaging and sensing sectors where crime prints could be detected on such different surfaces.
Author Contributions
K.B. and D.B.T. performed the experimentation for the application part of the material and contributed to writing the manuscript; A.K.D. and S.S synthesized and characterized the nanomaterials and contributed to the writing of the manuscript; V.K., J.S.M.S. and I.A.R. contributed to the scientific review of the manuscript and revision of the manuscript; S.S. conceptualized the theme of the manuscript and edited and reviewed the manuscript. All authors have read and agreed to the published version of the manuscript.
Funding
Thankful to Department of Biotechnology (DBT) for DBT-Ramalingaswamy research grant (BT/RLF/Re-entry/20/2017, awarded to S.S.) for completing this study. V.K. would like to thank the International Research Agendas PLUS programme of the Foundation for Polish Science, co-financed by the European Union under the European Regional Development Fund (MAB PLUS/2019/11).
Acknowledgments
Corresponding author S.S. is thankful to the DBT-Ramalingaswamy research grant (BT/RLF/Re-entry/20/2017, awarded to S.S.) for completing this study. Authors are also thankful to The Energy and Resources Institute (TERI), New Delhi, India. V.K. would like to thank the International Research Agendas PLUS programme of the Foundation for Polish Science, co-financed by the European Union under the European Regional Development Fund (MAB PLUS/2019/11).
Conflicts of Interest
The authors declare no conflict of interest.
References
- Li, H.; Zhang, C.; Wang, J.; Chong, H.; Zhang, T.; Wang, C. Pristine Graphic Carbon Nitride Quantum Dots for the Visualized Detection of Latent Fingerprints. Anal. Sci. 2021, 37, 1497–1503. [Google Scholar] [CrossRef] [PubMed]
- Hawthorne, M. Fingerprints: Analysis and Understanding; CRC Press: Boca Raton, FL, USA, 2017. [Google Scholar]
- Boone, L.L. Fingerprints. In Manual of Crime Scene Investigation; CRC Press: Boca Raton, FL, USA, 2023; pp. 181–192. [Google Scholar]
- Das, G.S.; Hwang, J.Y.; Jang, J.H.; Tripathi, K.; Kim, T.Y. Biomass based functionalized graphene for self rechargable zincair batteries. ACS Appl. Energy Mater. 2022, 5, 6663–66705. [Google Scholar] [CrossRef]
- Hutchins, L.A. Systems of Friction Ridge Classification; U.S. Department of Justice: Washington, DC, USA, 2007. [Google Scholar]
- Zhao, D.; Ma, W.; Xiao, X. The Recognition of Sweat Latent Fingerprints with Green-Emitting Carbon Dots. Nanomaterials 2018, 8, 612. [Google Scholar] [CrossRef] [PubMed]
- Prabakaran, E.; Pillay, K. Nanomaterials for Latent Fingerprint Detection—A Review. J. Mater. Res. Technol. 2021, 12, 1856–1885. [Google Scholar] [CrossRef]
- Sawhney, S.; Bhati, K.; Chhabra, P.; Tripathy, D. Role of Nanotechnology in Techniques in Fingerprints Enhancement. Indian J. Forensic Med. Pathol. 2021, 14, 288–294. [Google Scholar] [CrossRef]
- Abebe, B.; Chowdappa, H.; Murthy, A.; Zereffa, E.A.; Dessie, Y. Latent Fingerprint Enhancement Techniques: A Review. J. Chem. Rev. 2020, 2, 40–56. [Google Scholar] [CrossRef]
- Bhati, K. Role of Nanoparticles in Latent Fingerprinting: An Update. Lett. Appl. NanoBioSci. 2020, 9, 1427–1443. [Google Scholar] [CrossRef]
- Bhati, K.; Tripathy, D.; Chhabra, P. Role of Fluorescent Substances in Development of Latent Fingerprints: A Review. Indian J. Forensic Med. Pathol. 2021, 14, 351–358. [Google Scholar]
- Yang, L.; Zhang, Q.; Han, Y.; Li, H.; Sun, S.; Xu, Y. The Selective Deprotonation of Carbon Quantum Dots for Fluorescence Detection of Phosphate and Visualization of Latent Fingerprints. Nanoscale 2021, 13, 13057–13064. [Google Scholar] [CrossRef]
- Zhang, Q.; Zhao, Q.; Fu, M.; Fan, X.; Lu, H.; Wang, H.; Zhang, Y.; Wang, H. Carbon Quantum Dots Encapsulated in Super Small Platinum Nanocrystals Core-Shell Architecture/Nitrogen Doped Graphene Hybrid Nanocomposite for Electrochemical Biosensing of DNA Damage Biomarker-8-Hydroxy-2′-Deoxyguanosine. Anal. Chim. Acta 2019, 1047, 9–20. [Google Scholar] [CrossRef]
- Wang, H.-J.; Hou, W.-Y.; Yu, T.-T.; Chen, H.-L.; Zhang, Q.-Q. Facile Microwave Synthesis of Carbon Dots Powder with Enhanced Solid-State Fluorescence and Its Applications in Rapid Fingerprints Detection and White-Light-Emitting Diodes. Dye. Pigment. 2019, 170, 107623. [Google Scholar] [CrossRef]
- Verhagen, A.; Kelarakis, A. Carbon Dots for Forensic Applications: A Critical Review. Nanomaterials 2020, 10, 1535. [Google Scholar] [CrossRef]
- Fernandes, D.; Krysmann, M.J.; Kelarakis, A. Carbon Dot Based Nanopowders and Their Application for Fingerprint Recovery. Chem. Commun. 2015, 51, 4902–4905. [Google Scholar] [CrossRef] [PubMed]
- Chen, J.; Wei, J.-S.; Zhang, P.; Niu, X.-Q.; Zhao, W.; Zhu, Z.-Y.; Ding, H.; Xiong, H.-M. Red-Emissive Carbon Dots for Fingerprints Detection by Spray Method: Coffee Ring Effect and Unquenched Fluorescence in Drying Process. ACS Appl. Mater. Interfaces 2017, 9, 18429–18433. [Google Scholar] [CrossRef]
- Tang, M.; Ren, G.; Zhu, B.; Yu, L.; Liu, X.; Chai, F.; Wu, H.; Wang, C. Facile Synthesis of Orange Emissive Carbon Dots and Their Application for Mercury Ion Detection and Fast Fingerprint Development. Anal. Methods 2019, 11, 2072–2081. [Google Scholar] [CrossRef]
- Das, G.S.; Bhatnagar, A.; Pirila, P.Y.; Tripathi, K.M.; Kim, T.Y. Sustainable nitrogen-doped functionalized graphene nanosheets for visible-light-induced photocatalytic water splitting. Chem. Commun. 2020, 56, 6953. [Google Scholar] [CrossRef] [PubMed]
- Aggarwal, R.; Sonkar, S.K.; Tripathi, K.M. Visible-light promoted hydrogen production by diesel soot derived onion like carbon nanoparticles. Carbon 2023, 208, 436–442. [Google Scholar] [CrossRef]
- Kaushik, J.; Tripathi, K.M.; Singh, R.; Sonkar, S.K. Thiourea-functionalized graphene aerogel for the aqueous phase sensing of toxic Pb(II) metal ions and H2O2. Chemosphere 2022, 287, 132105. [Google Scholar] [CrossRef]
- Kumari, P.; Tripathi, K.M.; Awasthi, K.; Gupta, R. Sustainable carbon nano-onions as an adsorbent for the efficient removal of oxo-anions. Environ. Sci. Pollut. Res. 2023, 30, 15480–15489. [Google Scholar] [CrossRef]
- Chowdhury, S.N.; Tung, T.T.; Hoai, Q.T.; Castro, M.; Feller, J.F.; Sonkar, S.K.; Tripathi, K.M. Upgrading of diesel engine exhaust waste into onion-like carbon nanoparticles for integrated degradation sensing in nano-biocomposites. New J. Chem. 2021, 45, 3675–3682. [Google Scholar] [CrossRef]
- Jung, S.H.; Huong, P.T.; Sahani, S.; Tripathi, K.M.; Park, B.J.; Han, Y.H.; Kim, T.Y. Biomass-Derived Graphene-Based Materials Embedded with Onion-Like Carbons for High Power Supercapacitors. J. Electrochem. Soc. 2022, 169, 010509. [Google Scholar] [CrossRef]
- Das, G.S.; Sarkar, S.; Aggarwal, R.; Sonkar, S.K.; Park, J.W.; Tripathi, K.M.; Kim, T.Y. Fluorescent microspheres of zinc 1,2-dicarbomethoxy-1,2-dithiolate complex decorated with carbon nanotubes. Carbon Lett. 2019, 29, 595–603. [Google Scholar] [CrossRef]
- Dhiman, N.; Ghosh, S.; Mishra, Y.M.; Tripathi, K.M. Prospects of nano-carbons as emerging catalysts for enzyme-mimetic applications. Mater. Adv. 2022, 3, 3101–3122. [Google Scholar] [CrossRef]
- Qu, S.; Wang, X.; Lu, Q.; Liu, X.; Wang, L. A Biocompatible Fluorescent Ink Based on Water-Soluble Luminescent Carbon Nanodots. Angew. Chem. Int. Ed. 2012, 51, 12215–12218. [Google Scholar] [CrossRef] [PubMed]
- Nugroho, D.; Oh, W.C.; Chanthai, S.; Benchawattananon, R. Improving Minutiae Image of Latent Fingerprint Detection on Non-Porous Surface Materials under UV Light Using Sulfur Doped Carbon Quantum Dots from Magnolia Grandiflora Flower. Nanomaterials 2022, 12, 3277. [Google Scholar] [CrossRef]
- Gomes, S.A.O.; Vieira, C.S.; Almeida, D.B.; Santos-Mallet, J.R.; Menna-Barreto, R.F.S.; Cesar, C.L.; Feder, D. CdTe and CdSe Quantum Dots Cytotoxicity: A Comparative Study on Microorganisms. Sensors 2011, 11, 11664–11678. [Google Scholar] [CrossRef]
- Weng, M.; Sun, L.; Qu, S.; Chen, L. Fingerprint-inspired graphene pressure sensor with wrinkled structure. Extrem. Mech. Lett. 2020, 37, 100714. [Google Scholar] [CrossRef]
- Zhang, M.; Zhu, Y.; Yu, X.; Liu, S.; Wang, M.; Wei, Q.; Hu, X.; Tang, Q.; Zhao, Y.; Zhang, X. Application of Electrodepositing Graphene Nanosheets for Latent Fingerprint Enhancement. Electroanalysis 2014, 26, 209–215. [Google Scholar] [CrossRef]
Disclaimer/Publisher’s Note: The statements, opinions and data contained in all publications are solely those of the individual author(s) and contributor(s) and not of MDPI and/or the editor(s). MDPI and/or the editor(s) disclaim responsibility for any injury to people or property resulting from any ideas, methods, instructions or products referred to in the content. |
© 2023 by the authors. Licensee MDPI, Basel, Switzerland. This article is an open access article distributed under the terms and conditions of the Creative Commons Attribution (CC BY) license (https://creativecommons.org/licenses/by/4.0/).